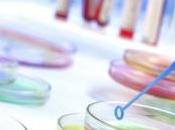
MÉDECINE RÉGÉNÉRATIVE: Castor veille cellules souches PNAS

Magazine Santé
 Sélection Paperblog Santé
Sélection Paperblog Santé
Psycho : Le sentiment de puissance plus fort que les préjugés
Deux influences sociales s’affrontent, selon ces chercheurs en sociologie de l’Indiana, la capacité personnelle et les préjugés subis. Lire la suite
 Sélection Paperblog Santé
Sélection Paperblog Santé
La douleur se lit dans la pupille
Le diamètre de la pupille ou encore sa contraction après une stimulation lumineuse de la rétine évoluent avec la douleur. Une équipe de recherche française vient de tester ces... Lire la suite
LES DERNIERS ARTICLES DES PAPERBLOGUEURS
-
MÉDECINE RÉGÉNÉRATIVE: Castor veille sur les cellules souches – PNAS
Comprendre au mieux comment les cellules souches se différencient en organes et tissus spécifiques est l’objectif ultime et incontournable de la médecine... Lire la suite
Le 24 avril 2013 par Santelog
-
BISPHÉNOL A: Nouveau rapport, nouveau projet d'interdiction – Anses et Ministre...

Alors que L’Agence nationale de sécurité sanitaire de l’alimentation, de l’environnement et du travail (Anses) publie ce jour son rapport sur l’évaluation des... Lire la suite
Le 09 avril 2013 par Santelog
-
Un tiers des enfants italiens ne va plus chez le dentiste
La crise économique est en train de gâcher le sourire des enfants du moment qu'"une famille sur trois ne les emmène plus chez le dentiste", a déclaré vendredi... Lire la suite
Le 25 avril 2013 par Dentisfuturis
-
CANNABIS: Usage intensif et maladie mentale irrésistiblement liées –...

Les personnes atteintes de maladies mentales sont plus de 7 fois plus susceptibles de consommer du cannabis chaque semaine, selon ces chercheurs du Centre... Lire la suite
Le 04 avril 2013 par Santelog
-
CHIRURGIE BARIATRIQUE : L'amélioration du diabète liée plutôt au régime ou plutô...

Le régime alimentaire désigné comme Le facteur crucial dans l’amélioration du diabète de type 2, avec ou sans chirurgie bariatrique, c’est la conclusion de ces... Lire la suite
Le 04 avril 2013 par Santelog
-
Accord National Interprofessionnel (ANI) : Le prix du compromis – Soins...

Voilà le gouvernement contraint de recourir à l’article 44-3 de la Constitution pour faire adopter, par le Sénat, le projet de loi relatif à la Sécurisation de... Lire la suite
Le 24 avril 2013 par Santelog
-
DROIT D'ALERTE en Santé et environnement: Les lanceurs seront protégés –...

Premier texte écologiste à avoir été adopté, en seconde lecture, par l’Assemblée, cette proposition de loi vise à protéger « les lanceurs d’alerte » sanitaires... Lire la suite
Le 04 avril 2013 par Santelog
-
Terre d’Artistes : Un CD au profit du comité 79 de la Ligue contre le cancer

La sortie du CD Terre d’artistes est prévue le 21 juin ! préparez vos oreilles ! En achetant le CD, vous soutenez la recherche contre le cancer. Lire la suite
Le 06 avril 2013 par Santelog
-
STRESS au travail: Le singe nous l'explique – General and Comparative...

Cette étude de l’Université de Manchester et de Liverpool sur le singe, illustre pourquoi ce sont les classes sociales intermédiaires qui souffrent le plus du... Lire la suite
Le 06 avril 2013 par Santelog
-
FUKUSHIMA: Fuite d'eau radioactive, la vigilance est de mise – IRSN

L’Institut de Radioprotection et de Sûreté Nucléaire informe, au 8 avril, d’une fuite de l’un voire de deux des réservoirs enterrés d’eau radioactive sur le sit... Lire la suite
Le 08 avril 2013 par Santelog
POUR ALLER PLUS LOIN
-
Omega 3: Faut-il manger du poisson pour vivre 2 années de plus?
Le 03 avril 2013 par Santelog :
-
« Ordinateur pour Tous » – MAJESTIC-Media LTe
Le 08 avril 2013 par Santelog :
-
LAnesthésie DENTAIRE peut stopper le développement des dents de sagesse
Le 30 avril 2013 par Dentisfuturis :
-
IVG remboursée pour toutes et gratuité de la pilule pour les mineures
Le 02 avril 2013 par Bypeople_fr :
-
SCLÉROSE latérale amyotrophique et cellules souches: La FDA approuve un essai de phase II – FDA
Le 20 avril 2013 par Santelog :
-
réduire les symptômes de la préménopause / trucs et astuces anti-bouffées de chaleur (3 de 3)
Le 12 avril 2013 par Nathalie Chausseau : Cuisine,
-
Dysfonction ÉRECTILE: Quel recours réel aux traitements? – euroClinix
Le 30 avril 2013 par Santelog :
-
INFECTIONS bactériennes: Des nano-éponges pour absorber les toxines – Nature Nanotechnology
Le 15 avril 2013 par Santelog :
-
PLAIES: Découverte de nouvelles enzymes qui favorisent la cicatrisation – Genetics Society of America
Le 08 avril 2013 par Santelog :
-
VIRUS H7N9: Les «wet markets» incriminés par une nouvelle étude – The Lancet- ECDC
Le 28 avril 2013 par Santelog :
-
Journée mondiale de l'autisme: Toutes les 11 minutes, un enfant est diagnostiqué
Le 03 avril 2013 par Santelog :
-
Des chercheurs génèrent des dents à partir des cellules de gencive prélevées sur
Le 25 avril 2013 par Dentisfuturis :
-
Un site de santé pour la peau : Peau.net
Le 22 avril 2013 par Santelog :
-
Un bracelet pour combattre les infections à l'hôpital
Le 09 avril 2013 par Pnordey : High tech,
-
ALCOOL: Des Français de plus en plus raisonnables? – Entreprise & Prévention
Le 11 avril 2013 par Santelog :
-
CANCER et diagnostic: Une superglue moléculaire pour assembler des biomarqueurs – ACS
Le 16 avril 2013 par Santelog :
-
HTA: Le jus de betterave réduit la pression artérielle – Hypertension
Le 18 avril 2013 par Santelog :
-
PARENTALITÉ et développement: L'affection peut-elle compenser la fessée? – Parenting: Science and...
Le 20 avril 2013 par Santelog :
-
VIRUS AVIAIRE H7N9: Le risque de propagation en Europe considéré comme faible – ECDC-DGS
Le 09 avril 2013 par Santelog :
-
INSUFFISANCE CARDIAQUE: Le gène qui pourrait rajeunir les vieux curs – Nature
Le 22 avril 2013 par Santelog :
LES PRÉCÉDENTS COUPS DE CŒUR PAPERBLOG
-

Asthmapolis place des capteurs sur les inhalateurs des asthmatiques
-

AVC: Une banane et son potassium pour réduire son risque
Le 07 avril 2013
-

Stress: Notre humeur du jour prédit notre santé mentale 10 ans plus tard
Le 07 avril 2013
-

Nouvelle recherche scientifique: Manger des protéines le matin réduit tes fringales et améliore ton...
Le 05 avril 2013 Coaching sportif
-

Ondes éléctromagnétiques: Et si elles diminuaient les réflexes ?
Le 04 avril 2013
 JOURNÉE MONDIALE SANS TABAC
JOURNÉE MONDIALE SANS TABAC
 OBÉSITÉ
OBÉSITÉ
 RÉFORME OBAMA
RÉFORME OBAMA
 SIDACTION
SIDACTION
 ALLERGIE AU POLLEN
ALLERGIE AU POLLEN
 LUTTE CONTRE LE SIDA
LUTTE CONTRE LE SIDA
 SUICIDE
SUICIDE
 HOMÉOPATHIE
HOMÉOPATHIE
 RHUME
RHUME
 STRESS
STRESS
 DÉPRESSION
DÉPRESSION
 LUMINOTHÉRAPIE
LUMINOTHÉRAPIE
 ASTHME
ASTHME
 GRIPPE PORCINE
GRIPPE PORCINE
 MALADIE D'ALZHEIMER
MALADIE D'ALZHEIMER
 CARIE DENTAIRE
CARIE DENTAIRE
